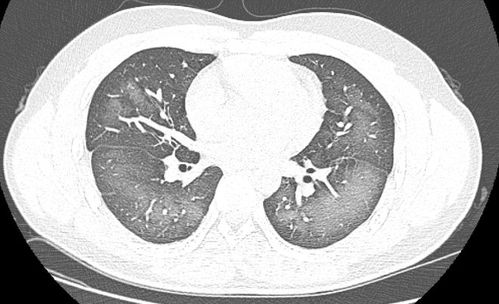

肺部变白是不是没救了:肺部变白是不是没救了?真相在这里!
在日常生活中,很多人听到“肺部变白”这个词,往往会联想到严重的疾病,甚至觉得“没救了”,这种误解可能源于对医学知识的不了解,肺部变白到底意味着什么?是不是真的没救了?今天我们就来一探究竟。
肺部变白的原因
肺部变白并不是一种具体的疾病,而是一种影像学表现,在X光、CT等检查中,肺部变白可能由以下原因引起:
肺炎:肺炎是肺部感染的一种常见疾病,炎症会导致肺部组织密度增加,在X光片上呈现为白色阴影,肺炎通常可以通过抗生素治疗,预后良好。
肺气肿:这是一种慢性肺部疾病,肺部气体交换功能下降,可能导致肺部透亮度增加,看起来“变白”,肺气肿通常与吸烟有关,虽然无法根治,但通过治疗可以控制症状。
肺纤维化:这是一种肺部组织瘢痕化的疾病,会导致肺部变硬、变厚,在影像上可能呈现白色,肺纤维化目前尚无特效治疗方法,但早期干预可以延缓病情进展。

肺结核:结核病是一种由结核分枝杆菌引起的感染,可能在肺部形成白色病灶,通过规范的抗结核治疗,大多数患者可以康复。
肺癌:虽然肺癌在影像上可能表现为白色阴影,但并非所有肺部变白都是肺癌,肺癌的诊断需要结合其他检查,如活检等。
肺部变白是不是没救了?
肺部变白并不意味着“没救了”,关键在于明确病因,及时治疗,无论是肺炎、肺气肿还是其他肺部疾病,只要早期发现、科学治疗,大多数情况下都能得到有效控制。
肺炎:如果及时就医,使用合适的抗生素,肺炎通常可以在一周内好转。
肺气肿:戒烟、药物治疗和肺康复训练可以有效缓解症状,延缓病情进展。
肺纤维化:虽然目前无法治愈,但通过规范治疗,可以减少肺部功能下降的速度,提高生活质量。
肺结核:早期发现并坚持完成全程治疗,治愈率高达90%以上。
肺癌:肺癌的预后与发现时的阶段密切相关,早期肺癌通过手术可以治愈,中晚期肺癌虽然治疗难度较大,但仍有多种治疗手段,如化疗、放疗、靶向治疗等,可以延长生存期。

为什么有人会认为肺部变白意味着没救了?
信息误导:网络上一些未经证实的信息可能夸大了肺部变白的严重性,导致人们产生误解。
对疾病的恐惧:肺癌等严重疾病容易让人产生“一白就完蛋”的想法,忽略了其他可能性。
缺乏医学知识:普通人对肺部影像学表现了解有限,容易将“变白”与“坏消息”挂钩。
建议
及时就医:如果发现肺部变白,不要恐慌,尽快到医院进行详细检查,明确病因。
定期体检:尤其是长期吸烟者、有肺部疾病家族史的人群,应定期进行肺部检查。
健康生活方式:戒烟、避免空气污染、保持良好的饮食习惯,都有助于保护肺部健康。
肺部变白并不等于“没救了”,关键在于科学诊断和规范治疗,与其被不实信息吓倒,不如积极面对,及时就医,健康掌握在自己手中,早发现、早治疗才是应对肺部疾病的正确方式!
相关文章:
文章已关闭评论!










